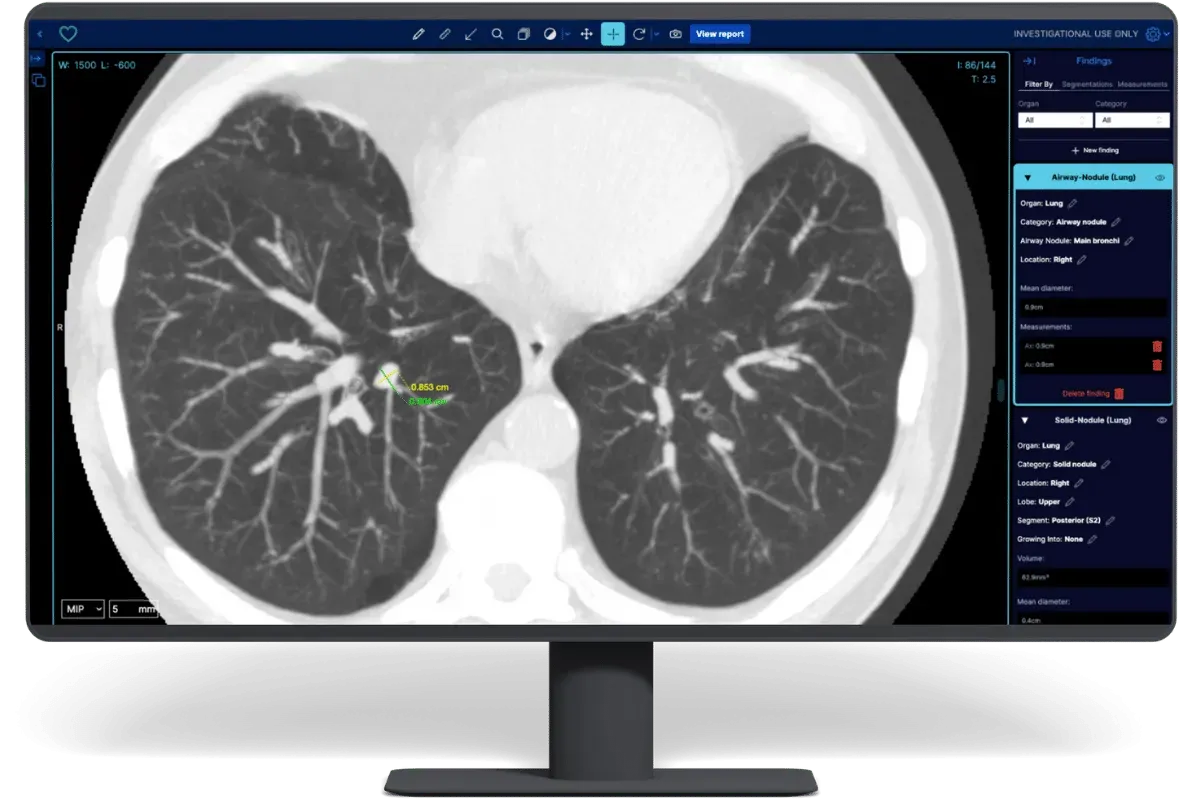
Estonia-based Better Medicine raises €1M for its AI-powered detection tool for kidney cancer

Better Medicine, a startup based in Tartu, Estonia that focuses on developing AI-powered software to detect lesions in CT scan imaging, has secured €1 million in pre-seed funding to accelerate the rollout of its AI-powered kidney cancer detection platform across Europe and its plans to break into the US market. The round was led by Soulmates Ventures, with participation from Specialist VC, UT Ventures, and angel investors.
The funding brings Better Medicine's total capital to nearly €6 million. Of the €6 million that Better Medicine has raised, €3.7 million comes from grants from the European Innovation Council and other sources, and €2.25 million was sourced from private funding. Founded in 2020, the company addresses critical challenges in radiology departments worldwide, which currently face a severe shortage of professionals. For instance, recent reports reveal that in the UK, about half of the available radiology job positions remain vacant, and there are only 10 working radiologists per 100,000 inhabitants.
Better Medicine's flagship product, BMVision Kidney, recently became the first AI-based kidney cancer detection tool to receive CE certification under the EU Medical Device Regulation. The platform integrates directly into radiologists' workflows, detecting malignant kidney lesions in CT scans with 96% standalone accuracy and 99.2% detection rate when combined with radiologist assessment.
Clinical evaluations show radiologists using BMVision achieve up to 52% time savings while maintaining high diagnostic accuracy. The technology aims to reduce the estimated 12 million hours spent globally on manual lesion measurements annually.
"We are making early cancer detection easy and freeing doctors to avoid burnout," said CEO Priit Salumaa. The new funding will support European expansion and preparation for FDA clearance through clinical trials satisfying the agency's study requirements.

Comments